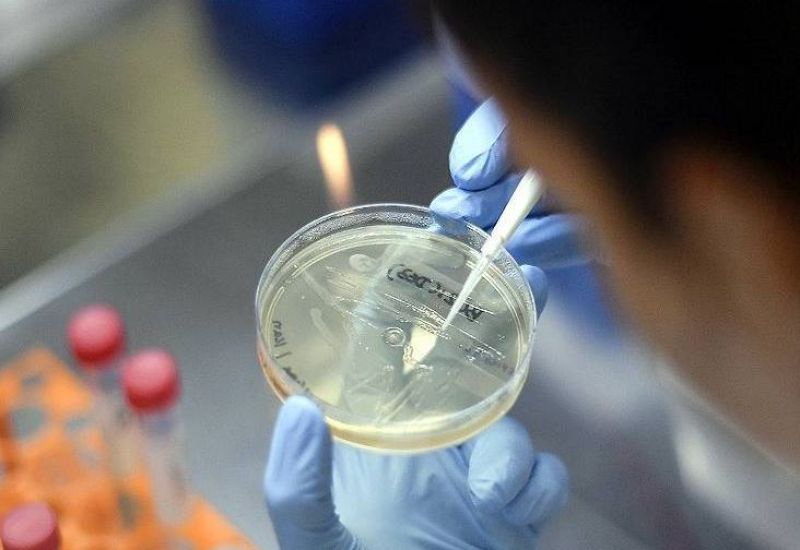
Corona Virus

8 ਲੱਖ 20 ਹਜ਼ਾਰ ਤੋਂ ਵੱਧ ਹੋਏ ਸੰਕਰਮਣ ਦੇ ਮਾਮਲੇ
ਕੋਰੋਨਾ ਵਾਇਰਸ ਨਾਲ ਸੰਕਰਮਣ ਦੇ ਮਾਮਲੇ ਵੱਧ ਰਹੇ ਹਨ। ਪਿਛਲੇ 24 ਘੰਟਿਆਂ ਵਿਚ 27 ਹਜ਼ਾਰ 114 ਨਵੇਂ ਕੇਸ ਸਾਹਮਣੇ ਆਏ ਹਨ। ਇਸ ਸਮੇਂ ਦੌਰਾਨ 519 ਮੌਤਾਂ ਵੀ ਹੋ ਚੁੱਕੀਆਂ ਹਨ। ਦੇਸ਼ ਵਿਚ ਕੋਰੋਨਾ ਵਾਇਰਸ ਦੀ ਲਾਗ ਦੇ ਮਾਮਲੇ ਅੱਠ ਲੱਖ ਨੂੰ ਪਾਰ ਕਰ ਗਏ ਹਨ।
 Corona Virus
Corona Virus
ਕੋਰੋਨਾ ਤੋਂ ਸੰਕਰਮਣ ਦੇ 8 ਲੱਖ 20 ਹਜ਼ਾਰ 916 ਮਾਮਲੇ ਸਾਹਮਣੇ ਆਏ ਹਨ। ਇਸ ਦੇ ਨਾਲ ਹੀ ਦੇਸ਼ ਵਿਚ ਮਰਨ ਵਾਲਿਆਂ ਦੀ ਗਿਣਤੀ ਵੀ 22 ਹਜ਼ਾਰ 163 ਹੋ ਗਈ ਹੈ। ਦੇਸ਼ ਵਿਚ ਕੋਰੋਨਾ ਦੀ ਲਾਗ ਦੇ 2 ਲੱਖ 83 ਹਜ਼ਾਰ 407 ਸਰਗਰਮ ਮਾਮਲੇ ਹਨ। ਹੁਣ ਤੱਕ 5 ਲੱਖ 15 ਹਜ਼ਾਰ 386 ਸੰਕਰਮਿਤ ਤੰਦਰੁਸਤ ਹੋ ਚੁੱਕੇ ਹਨ।
 corona virus
corona virus
ਕੋਰੋਨਾ ਵਾਇਰਸ ਦੀ ਜਾਂਚ ਵੀ ਹੁਣ ਵੱਧ ਰਹੀ ਹੈ। 10 ਜੁਲਾਈ ਨੂੰ ਦੇਸ਼ ਵਿਚ 2 ਲੱਖ 82 ਹਜ਼ਾਰ 511 ਨਮੂਨੇ ਦੇ ਟੈਸਟ ਲਏ ਗਏ ਸਨ। ਆਈਸੀਐਮਆਰ ਦੇ ਅਨੁਸਾਰ ਦੇਸ਼ ਵਿਚ ਹੁਣ ਤੱਕ 1 ਕਰੋੜ 13 ਲੱਖ 7 ਹਜ਼ਾਰ 2 ਟੈਸਟ ਕੀਤੇ ਜਾ ਚੁੱਕੇ ਹਨ।
 Corona virus
Corona virus
ਸਿਹਤ ਅਤੇ ਪਰਿਵਾਰ ਭਲਾਈ ਮੰਤਰਾਲੇ ਦੁਆਰਾ ਜਾਰੀ ਕੀਤੇ ਗਏ ਅੰਕੜਿਆਂ ਅਨੁਸਾਰ ਦੇਸ਼ ਵਿਚ ਕੋਰੋਨਾ ਤੋਂ ਰਿਕਵਰੀ ਰੇਟ 62.78% ਹੈ। ਦੱਸ ਦਈਏ ਕੀ ਦੁਨੀਆ ਦੇ ਦੇਸ਼ਾਂ ਵਿਚੋਂ ਅਮਰੀਕਾ ਕੋਰੋਨਾ ਵਾਇਰਸ ਸੰਕਟ ਦਾ ਸਭ ਤੋਂ ਵੱਧ ਸ਼ਿਕਾਰ ਹੈ।
 Corona virus
Corona virus
ਪਿਛਲੇ 24 ਘੰਟਿਆਂ ਵਿਚ ਅਮਰੀਕਾ ਵਿਚ ਕੋਰੋਨਾ ਦੇ 70,000 ਤੋਂ ਵੱਧ ਮਾਮਲੇ ਸਾਹਮਣੇ ਆਏ ਹਨ। ਜੋ ਕਿ ਕਿਸੇ ਵੀ ਦੇਸ਼ ਵਿਚ ਮਹਾਂਮਾਰੀ ਸ਼ੁਰੂ ਹੋਣ ਤੋਂ ਬਾਅਦ ਦੀ ਸਭ ਤੋਂ ਵੱਡੀ ਛਾਲ ਹੈ। ਜੌਨ ਹਾਪਕਿਨਜ਼ ਯੂਨੀਵਰਸਿਟੀ ਦੇ ਅੰਕੜਿਆਂ ਦੇ ਅਨੁਸਾਰ, ਸੰਯੁਕਤ ਰਾਜ ਵਿਚ ਹੁਣ ਤੱਕ 3,183,856 ਲੋਕ ਕੋਰੋਨਾ ਤੋਂ ਪੀੜਤ ਹਨ।
Corona Virus
Corona Virus
ਜੌਨ ਹਾਪਕਿਨਜ਼ ਯੂਨੀਵਰਸਿਟੀ ਦੇ ਅੰਕੜੇ ਦਸਦੇ ਹਨ ਕਿ ਵਿਸ਼ਵ ਭਰ ਵਿਚ ਹੁਣ ਤੱਕ 12,461,962 ਲੋਕ ਮਾਰੂ ਕੋਰੋਨਾ ਵਾਇਰਸ ਨਾਲ ਸੰਕਰਮਿਤ ਹੋਏ ਹਨ। ਇਸ ਖਤਰਨਾਕ ਵਾਇਰਸ ਕਾਰਨ ਹੁਣ ਤੱਕ ਵਿਸ਼ਵ ਵਿਚ 559,481 ਲੋਕ ਆਪਣੀਆਂ ਜਾਨਾਂ ਗੁਆ ਚੁੱਕੇ ਹਨ।
Punjabi News ਨਾਲ ਜੁੜੀ ਹੋਰ ਅਪਡੇਟ ਲਗਾਤਾਰ ਹਾਸਲ ਕਰਨ ਲਈ ਸਾਨੂੰ Facebook ਤੇ ਲਾਈਕ Twitter ਤੇ follow ਕਰੋ।

















